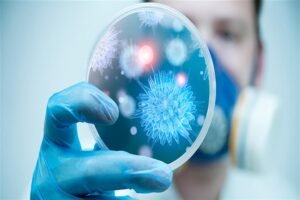
المدونة 130 الأمراض المعدية

- August 31, 2024
صحة العيون لكبار السن – كيف تحافظ على صحة عيونك؟
تعتبر صحة العيون لكبار السن من الجوانب الأساسية للرعاية...

- August 11, 2024
التكنولوجيا في الرعاية المنزلية – فوائدها وأبرز أنواعها
تبرز التكنولوجيا كعامل محوري في تحسين جودة الرعاية المنزلية...

- August 10, 2024
تجهيز المنزل لاستقبال الرعاية الصحية
تجهيز المنزل لاستقبال الرعاية الصحية قد يكون من أكثر...

- August 8, 2024
كيف تختار مقدم خدمة الرعاية المنزلية المناسب
كيف يمكنك التأكد من أن أحبائك الأكبر سناً يتلقون...

- August 7, 2024
الرعاية المنزلية لكبار السن – مركز بلسم الطبي
هل فكرت يوماً في كيفية تحسين جودة حياة أحبائك...

- August 6, 2024
تعرف على أمراض القلب والشرايين عند كبار السن
أمراض القلب والشرايين تعد من أبرز التحديات الصحية التي...

- August 5, 2024
العناية بالعيون لمرضى السكري – كيف يؤثر السكري على العينين؟
العناية بالعيون لمرضى السكري تعد من أهم جوانب الرعاية...

- August 5, 2024
الشلل الرعاش والأمراض العصبية عند كبار السن
ما هو الشلل الرعاش والأمراض العصبية؟ تعتبر الأمراض العصبية...

- August 5, 2024
تعرف على أمراض الكلى المزمنة عند كبار السن
أمراض الكلى المزمنة تعتبر من أكثر الأمراض شيوعًا بين...

- August 5, 2024
مقارنة بين العدسات اللاصقة والنظارات
هل تبحث عن مقارنة بين العدسات اللاصقة والنظارات؟ تعد...

- August 5, 2024
ما هو العلاج الطبيعي؟ فوائده وخطوات تنفيذه
العلاج الطبيعي هو مفتاح الشفاء الطبيعي واستعادة الحركة والنشاط،...

- August 5, 2024
العلاج الطبيعي لكبار السن – كيفية البدء وأبرز التقنيات
لماذا العلاج الطبيعي لكبار السن مهم؟ في مرحلة الشيخوخة،...

- August 5, 2024
العلاج الطبيعي العصبي – ما هو؟ وماذا يقدم لك؟
تخيل أن حياتك تمثل لوحة فنية تحتاج إلى ترميم...

- August 5, 2024
العلاج بالتدليك – فوائده وأنواعه ومحاذير استخدامه
تخيل أنك تستلقي في مكان هادئ، يحيط بك عطر...

- July 23, 2024
أمراض الجهاز التنفسي عند كبار السن – الأمراض الشائعة
تعد أمراض الجهاز التنفسي عند كبار السن من أكثر...

- July 22, 2024
سلس البول عند كبار السن – الأعراض والأسباب
هل تعلم أن الكثير من كبار السن يعانون من...


- June 17, 2024
الأمراض العصبية العضلية: الأسباب، الأعراض، والعلاج
تعد الأمراض العصبية العضلية من الحالات الصحية التي تؤثر...

- June 17, 2024
متلازمة القولون العصبي: الأسباب، الأعراض، والعلاج
تعد متلازمة القولون العصبي (IBS) من أكثر الاضطرابات الوظيفية...
- June 16, 2024
الأمراض المعدية: الأسباب، الأعراض، والعلاج
تعتبر الأمراض المعدية من القضايا الصحية الأساسية التي تؤثر...

- June 16, 2024
أمراض الحساسية: الأسباب، الأعراض، والعلاج
تعتبر أمراض الحساسية من الحالات الطبية الشائعة التي تؤثر...

- June 15, 2024
أمراض الجهاز الهضمي: الأسباب، الأعراض، والعلاج
يعتبر الجهاز الهضمي من أهم أجهزة الجسم، حيث يقوم...

- June 14, 2024
جلطات الدماغ: الأسباب، الأعراض والعلاج
تعد الجلطات واحدة من أكثر الحالات الطبية خطورة وتأثيرًا...

- June 14, 2024
أفضل عيادات المخ والأعصاب في السعودية
يعد المخ والجهاز العصبي من أكثر الأجزاء تعقيداً وأهمية...

- June 10, 2024
أهم المعلومات عن جراحة تصحيح البصر
تعد جراحة تصحيح البصر واحدة من أهم الابتكارات الطبية...



- June 10, 2024
رعاية كبار السن في المنزل – خدمات رعاية المسنين
رعاية كبار السن في المنزل تتطلب الكثير من الحب...

- June 10, 2024
خدمات الأشعة المنزلية في السعودية
في عصرنا الحالي، أصبحت خدمات الرعاية الصحية أكثر تنوعًا...

- June 9, 2024
أنواع خدمات الرعاية المنزلية
تعد خدمات الرعاية المنزلية أحد الحلول الفعالة التي تلبي...

- June 8, 2024
آلام المفاصل عند كبار السن: الأسباب والعلاج
تعتبر آلام المفاصل عند كبار السن مشكلة شائعة يعاني...


- June 3, 2024
مرض الزهايمر: الأسباب، الأعراض، التشخيص، والعلاج
مع التقدم في العمر، يواجه كبار السن العديد من...

- June 2, 2024
أمراض كبار السن: رعاية متكاملة لضمان جودة الحياة
مع التقدم في العمر، يواجه كبار السن العديد من...

- June 2, 2024
أفضل عيادات كبار السن في السعودية
تعتبر عيادات كبار السن من المرافق الصحية الهامة التي...

- May 28, 2024
آلام المفاصل: رفيقٌ كبار السن المُزعج
آلام المفاصل: رفيقٌ كبار السن المُزعج التهابات المفاصل تعد...